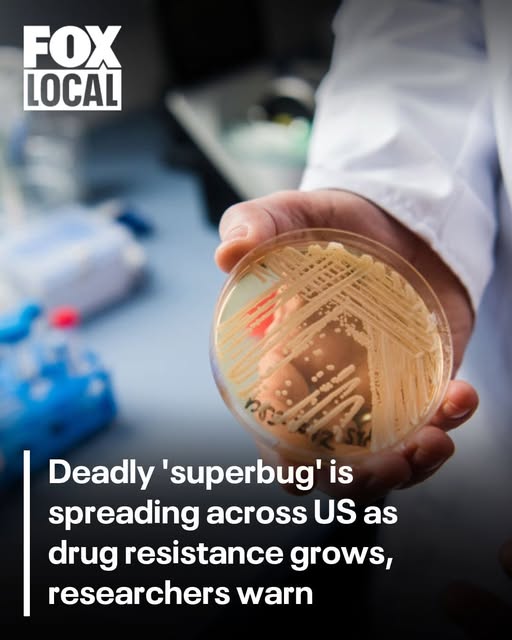

Deadly ‘superbug’ is spreading across US as drug resistance grows, researchers warn

Candida auris is a drug-resistant fungus spreading in hospitals worldwide. (Nicolas Armer/Picture Alliance via Getty Images)
A deadly, drug-resistant fungus already spreading rapidly through U.S. hospitals is becoming even more threatening worldwide, though there may be hope for new treatments, according to a new scientific review.
Candida auris (C. auris), often described as a “superbug fungus,” is spreading globally and increasingly resisting human immune systems, Hackensack Meridian Center for Discovery and Innovation (CDI) researchers said in a review published in early December.
The findings reinforce prior CDC warnings that have labeled C. auris an “urgent antimicrobial threat” — the first fungal pathogen to receive that designation — as U.S. cases have surged, particularly in hospitals and long-term care centers.
Approximately 7,000 cases were identified across dozens of U.S. states in 2025, according to the CDC, and it has reportedly been identified in at least 60 countries.
The review, published in Microbiology and Molecular Biology Reviews, helps explain why the pathogen is so difficult to contain and warns that outdated diagnostics and limited treatments lag behind. It was conducted by Dr. Neeraj Chauhan of the Hackensack Meridian CDI in New Jersey, Dr. Anuradha Chowdhary of the University of Delhi’s Medical Mycology Unit and Dr. Michail Lionakis, chief of the clinical mycology program at the National Institutes of Health.
Their findings stress the need to develop “novel antifungal agents with broad-spectrum activity against human fungal pathogens, to improve diagnostic tests and to develop immune- and vaccine-based adjunct modalities for the treatment of high-risk patients,” the researchers said in a statement.
“In addition, future efforts should focus on raising awareness about fungal disease through developing better surveillance mechanisms, especially in resource-poor countries,” they added. “All these developments should help improve the outcomes and prognosis of patients afflicted by opportunistic fungal infections.”
First identified in 2009 from a patient’s ear sample in Japan, C. auris has since spread to dozens of countries, including the U.S., where outbreaks have forced some hospital intensive care units to shut down, according to the researchers.
The fungus poses the greatest risk to people who are already critically ill, particularly those on ventilators or with weakened immune systems. Once infected, about half of patients may die, according to some estimates.
Unlike many other fungi, C. auris can survive on human skin and cling to hospital surfaces and medical equipment, allowing it to spread easily in healthcare settings.
“It is resistant to multiple antifungal drugs, and it tends to spread in hospital settings, including on equipment being used on immunocompromised and semi-immunocompromised patients, such as ventilators and catheters,” Dr. Marc Siegel, Fox News senior medical analyst and clinical professor of medicine at NYU Langone, previously told Fox News Digital.
It is also frequently misdiagnosed, delaying treatment and infection control measures.
“Unfortunately, symptoms such as fever, chills and aches may be ubiquitous, and it can be mistaken for other infections,” Siegel said.
In September, he said intense research was ongoing to develop new treatments.
Only four major classes of antifungal drugs are currently available, and C. auris has already shown resistance to many of them. While three new antifungal drugs have been approved or are in late-stage trials, researchers warn that drug development has struggled to keep pace with the fungus’s evolution.
Despite the sobering findings, there is still room for cautious optimism.
In separate research published in December, scientists at the University of Exeter in England discovered a potential weakness in C. auris while studying the fungus in a living-host model.
The team found that, during infection, the fungus activates specific genes to scavenge iron, a nutrient it needs to survive, according to their paper, published in the Nature portfolio journal Communications Biology in December.
Because iron is essential for the pathogen, researchers believe drugs that block this process could eventually stop infections or even allow existing medications to be repurposed.
“We think our research may have revealed an Achilles’ heel in this lethal pathogen during active infection,” Dr. Hugh Gifford, a clinical lecturer at the University of Exeter and co-author of the study, said in a statement.
As researchers race to better understand the fungus, officials warn that strict infection control, rapid detection and continued investment in new treatments remain critical.